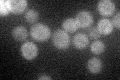
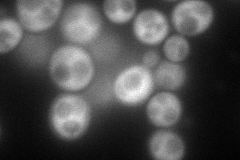
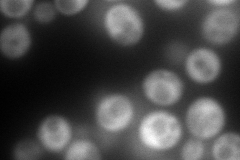
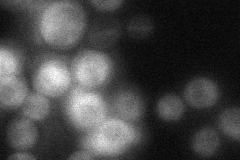
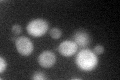
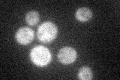

View description
Cytoplasmic RNA-binding protein, contains an RNA recognition motif (RRM); may have a role in mRNA translation, as suggested by genetic interactions with genes encoding proteins involved in translational initiation
Localization:
Intensity:
Fold change:
Significance:
-
C’ GFP library in SD
cytosol30.04 -
N' NOP1pr-GFP in SD
cytosol152.228 -
N' TEF2pr-mCherry in SD
cytosol230.833 -
N' NATIVEpr-GFP in SD
cytosol35.4188 -
N' TEF2pr-VC and Cyto-VN in SD

cytosol67.6213 -
C’ GFP library in SD+DTT
cytosol34.491.14No -
C’ GFP library in SD+H2O2

cytosol19.720.65No -
C’ GFP library in Starvation Media
cytosol37.411.24No -
C’ GFP library on the background of Pup2-DaMP

cytosol -
C’ GFP library on the background of CCT mutant

cytosol31.29671.04146No
